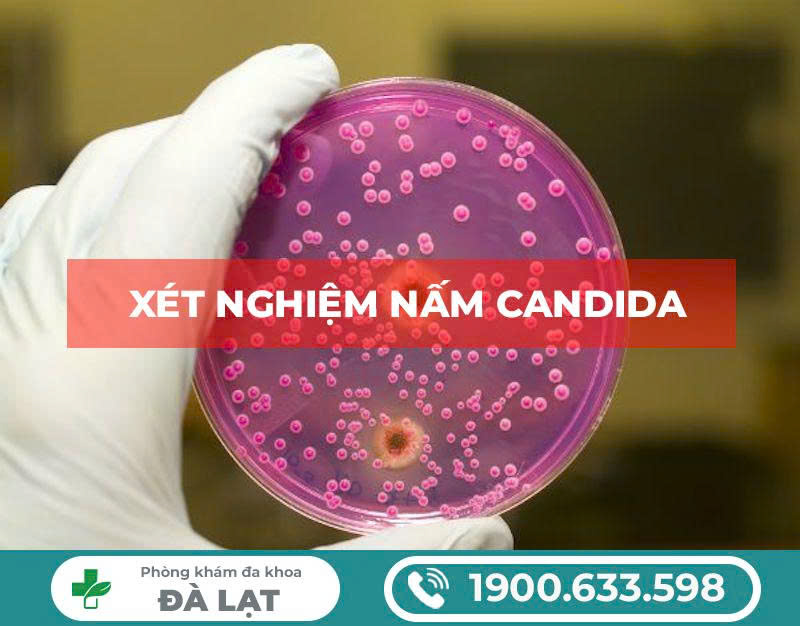
Hình ảnh minh họa

Messengerbây giờ
Bạn có thông báo mới!


59 Đoàn Thị Điểm
Phường 4, TP.Đà Lạt
Phường 4, TP.Đà Lạt

1900.633.598
0346.335.988

- Trang Chủ
- Giới Thiệu
- Hỏi bác sĩ
-
-
Nam Khoa +
- Liệt Dương
- Xuất Tinh Sớm
- Rối Loạn Cường Dương
- Yếu Sinh Lý
- Cắt Bao Quy Đầu
- Viêm Tinh Hoàn
- Viêm Niệu Đạo
- Viêm Bàng Quang
- Bệnh Tuyến Tiền Liệt
- Tiểu Nhiều
- Vô Sinh
- Phòng Khám Bệnh Nam Giới
- Tinh Trùng Bất Thường
- Dài Bao Quy Đầu
- Hẹp Bao Quy Đầu
- Gắn Bi Dương Vật
- Viêm Quy Đầu
- Viêm Đường Tiết Niệu
- Viêm Túi Tinh
- Viêm Nhiễm Dương Vật
- Tiểu Buốt, Tiểu Rắt Nam
- Đứt dây hãm bao quy đầu
- Nấm Quy Đầu
- Sưng Dương Vật
- Teo Tinh Hoàn
- Giang Mai
- Lậu
-
Phụ Khoa +
- Bệnh Cổ Tử Cung
- Bệnh Polyp Cổ Tử Cung
- Nang Naboth Cổ Tử Cung
- Viêm Tử Cung
- Viên Lộ Tuyến Cổ Tử Cung
- Viêm Nội Mạc Tử Cung
- Viêm Đường Tiết Niệu Nữ
- Tiểu Buốt, Tiểu Rắt Nữ
- Viêm Âm Đạo
- Viêm Âm Hộ
- Viêm Nhiễm Phụ Khoa
- Viêm Phần Phụ
- Viêm Tuyến Bartholin
- Viêm Vùng Chậu
- Khí Hư Bất Thường
- Nấm Vùng Kín
- Viêm Ống Dẫn Trứng
- Tắc Ống Dẫn Trứng
- Buồng Trứng Đa Nang
- Viêm Buồng Trứng
- U Nang Buồng Trứng
- Bệnh Kinh Nguyệt
- Vô Sinh Nữ
- Ngứa Âm Hộ
- Phòng Khám Bệnh Phụ Khoa
- Thẩm Mỹ Vùng Kín
- Thu Nhỏ Âm Đạo
- Cắt Môi Âm Đạo
- Vá Màng Trinh
-
Mụn Sinh Dục +
-
Bệnh Xã Hội +
-
- Khuyến Mại
ĐẶT HẸN KHÁM ➝
Hotline liên hệ
1900 633 598
0346 335 988






Bác sĩ đang yêu cầu chat với bạn !